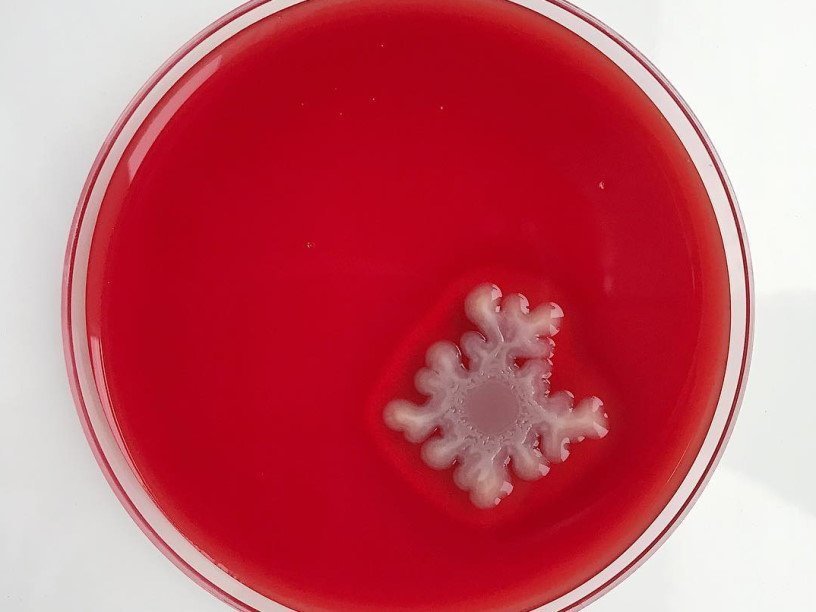

Екатерина Беленко: Промикробы: Видоизмененный азот
Фото: Екатерина Беленко Неделю назад я упомянула азотфиксацию, говоря об актиномицетах, пообещав рассказать поподробнее. Сегодня попытаюсь выполнить данное обещание. Эта тема далека от медицины, но ведь и микробиология медициной не ограничивается. Поэтому усаживайтесь поудобнее и готовьтесь вспоминать химию и ботанику.
⠀
Азот — очень распространённый в природе элемент, он содержится в живых организмах, в огромных количествах находится в почве. В воздухе азот присутствует в виде газа N2. Однако этот газ, содержание которого в атмосфере достигает 78 % по объёму, эукариоты сами по себе ассимилировать не могут. А уникальной способностью превращать N2 в азотсодержащие соединения обладают некоторые бактерии, которые называют азотфиксирующими, или азотфиксаторами. Это важнейший источник азота в биологическом круговороте. В наземных экосистемах азотфиксаторы локализуются, в основном, в почве.
⠀
Атомы в молекуле азота связаны прочной тройной ковалентной связью, из-за чего он практически не вступает в реакции без применения катализаторов и не может использоваться растениями и животными. Микроорганизмы для восстановления азота используют целую серию ферментов, важнейшим из которых является нитрогеназа. Гены, ответственные за ее синтез, широко распространены у прокариот, но не встречаются у эукариот. Процесс азотфиксации достаточно энергоемкий, для ассимиляции 1 молекулы азота требуется не менее 12 молекул АТФ, то есть для использования 1 мг азота анаэробным микроорганизмам требуется около 500 мг сахарозы.
⠀
Этим энергозатратным делом могут заниматься свободноживущие бактерии самых разнообразных родов и видов, но есть те, кто удобно устроился в тесном соседстве с растениями. Микробики, поселившиеся в прикорневой зоне или на поверхности листьев, занимаются ассоциативной азотфиксацией. Чем это лучше, спросите вы? Да тем, что они живут на шведском столе органических соединений. А есть те малыши, которые пошли ещё дальше, вступив в симбиоз. Наиболее известен симбиоз клубеньковых бактерий (сем. Rhizobiaceae) с бобовыми растениями. Бактерии рода Rhizobium семейства Rhizobiaceae — это грамотрицательные почвенные жители. Кроме бобовых, они ещё и с представителями семейства коноплевых умеют находить общий язык. А впервые их выделил нидерландский учёный Бейеринк аж в 1888 году. Совпадение?
⠀
Бактерии колонизируют клетки корня растения, образуя корневые клубеньки. Внутри клубеньков своя атмосфера — пониженное содержание кислорода, что является для них непременным условием. Клубеньковые бактерии фиксируют азот, который затем преобразуется в аммиак. Далее аммиак используется для постройки нуклеотидов, аминокислот и витаминов, которые необходимы для роста растений. В обмен растение поставляет бактериям сахара, образовавшиеся в ходе фотосинтеза, и обеспечивает им анаэробные (бескислородные) условия. Все довольны, одним словом. Созданы даже специальные бактериальные удобрения для заражения штаммами клубеньковых бактерий семян бобовых культур, что увеличивает их урожайность.
⠀
На превращении атмосферного азота в аммиак работа микробов не заканчивается: аммиак, получающийся в процессе биогенной фиксации, ещё может окисляться до нитратов и нитритов. Этот процесс носит название нитрификации, он осуществляется нитрифицирующими бактериями. Однако нет такой бактерии, которая бы прямо превращала аммиак в нитрат. В его окислении всегда участвуют две группы бактерий: одни окисляют аммиак, образуя нитрит, а другие окисляют нитрит в нитрат. Наиболее известные виды нитрифицирующих бактерий — это Nitrosomonas и Nitrobacter. Бактерии, окисляющие аммиак, поставляют субстрат для бактерий, окисляющих нитрит. Поскольку высокие концентрации аммиака оказывают на Nitrobacter токсическое действие, Nitrosomonas, используя аммиак и образуя кислоту, тем самым улучшает и условия существования для Nitrobacter. Ещё один пример крутого симбиоза и взаимовыручки.
Смотрите также: Екатерина Беленко Промикробы: Универсальная кислота Екатерина Беленко Промикробы: Зона комфорта Екатерина Беленко Промикробы: моча, окутанная мифами Екатерина Беленко Среда для микробиологов